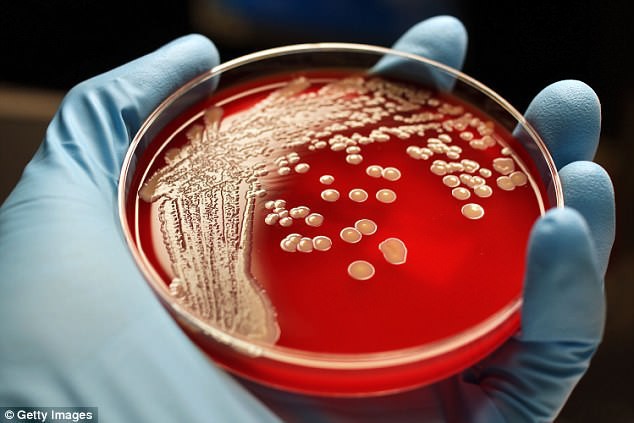
Báo cáo mới nhất về tình hình kháng kháng sinh tại Mỹ: Siêu vi khuẩn lây lan ngoài sức tưởng tượng

-
 Tin mới nhất về bão số 1 Maysak: Diễn biến khó lường, đêm 3/7 - 5/7 mưa rất to ở Đông Bắc Bộ, Thanh Hóa
Tin mới nhất về bão số 1 Maysak: Diễn biến khó lường, đêm 3/7 - 5/7 mưa rất to ở Đông Bắc Bộ, Thanh Hóa -
 Bố mẹ nói cho vay 200 triệu xây nhà, con gái đếm lại phát hiện 300 triệu, quyết định sau đó khiến chồng đòi ly hôn
Bố mẹ nói cho vay 200 triệu xây nhà, con gái đếm lại phát hiện 300 triệu, quyết định sau đó khiến chồng đòi ly hôn -
 PNJ chịu áp lực bán mạnh, cổ phiếu giảm sàn sau thông tin điều tra liên quan công ty thành viên
PNJ chịu áp lực bán mạnh, cổ phiếu giảm sàn sau thông tin điều tra liên quan công ty thành viên -
 Cháy căn nhà 4 tầng ở Hà Nội lúc 13h khiến hàng xóm hoảng loạn: Nghi có người còn mắc kẹt bên trong
Cháy căn nhà 4 tầng ở Hà Nội lúc 13h khiến hàng xóm hoảng loạn: Nghi có người còn mắc kẹt bên trong -
 Chưa từng có trong lịch sử thi cử: 7 số báo danh liền nhau đạt điểm 10 Toán tốt nghiệp ở Tuyên Quang
Chưa từng có trong lịch sử thi cử: 7 số báo danh liền nhau đạt điểm 10 Toán tốt nghiệp ở Tuyên Quang -
 Diễn biến mới nhất vụ cụ bà đột quỵ 5 năm chưa nhận trợ cấp BHXH: Lãnh đạo phường phản hồi
Diễn biến mới nhất vụ cụ bà đột quỵ 5 năm chưa nhận trợ cấp BHXH: Lãnh đạo phường phản hồi -
 Lời kể của bé 5 tuổi nghi bị bạo hành ở Tây Ninh: Bị cô giáo đánh đến chảy máu, vùi đầu vào xô nước?
Lời kể của bé 5 tuổi nghi bị bạo hành ở Tây Ninh: Bị cô giáo đánh đến chảy máu, vùi đầu vào xô nước? -
 Thông tin về vụ đắm tàu cá chở 7 người ở Quảng Ninh, danh tính thuyền trưởng đang mất tích
Thông tin về vụ đắm tàu cá chở 7 người ở Quảng Ninh, danh tính thuyền trưởng đang mất tích -
 Vụ người phụ nữ “ngã vờ” ăn vạ tài xế tại Hải Tiến: Người trong cuộc lên tiếng nhận sai
Vụ người phụ nữ “ngã vờ” ăn vạ tài xế tại Hải Tiến: Người trong cuộc lên tiếng nhận sai -
 Công an xác minh gần 150 điểm 10 Toán ở THPT chuyên Tuyên Quang
Công an xác minh gần 150 điểm 10 Toán ở THPT chuyên Tuyên Quang
Thế giới
06/04/2018 06:29Báo cáo mới nhất về tình hình kháng kháng sinh tại Mỹ: Siêu vi khuẩn lây lan ngoài sức tưởng tượng
Mới đây, Cơ quan Phòng ngừa và Kiểm soát dịch bệnh Hoa Kỳ (CDC) công bố một bản báo cáo về tình hình kháng kháng sinh ở Mỹ. Theo đó, trong 9 tháng năm 2017, nước Mỹ ghi nhận 221 trường hợp nhiễm trùng kháng hầu hết hoặc tất cả các loại kháng sinh hiện có.
Cứ mỗi 10 người ở Mỹ từng tiếp xúc với một người mang mầm bệnh kháng kháng sinh thì có 1 người bị lây sang, dù cho họ có hay không hề có triệu chứng. Và cứ mỗi 4 mầm bệnh lại có một gen kháng thuốc có thể lây truyền sang các vi khuẩn khác.
Những siêu vi khuẩn này đang giết chết 23.000 người ở Mỹ mỗi năm. Báo cáo mới của CDC nằm trong kế hoạch phát triển một chiến lược “hành động sớm và mạnh mẽ" nhằm giữ cho những siêu vi khuẩn khỏi lây lan.

Chúng ta biết rằng vi khuẩn sẽ tiến hóa để kháng lại tất cả các loại kháng sinh của con người. Để đối phó với điều này, năm 2016, CDC đã thành lập một Mạng lưới Phòng thí nghiệm Kháng kháng sinh trên toàn nước Mỹ (bao gồm 1 Trung tâm Xét nghiệm Phân tử Quốc gia về bệnh lao, 7 phòng thí nghiệm vùng và ít nhất 1 phòng thí nghiệm tại mỗi tiểu bang) nhằm theo dõi tình hình.
Trong một báo cáo mới đây nhất của hệ thống này, CDC đã đã xác định được hơn 220 trường hợp liên quan đến vi khuẩn mang gen hiếm gặp, khiến cho chúng kháng được hầu hết hoặc tất cả các loại kháng sinh hiện có trên 27 tiểu bang.
"Tôi rất ngạc nhiên, đó là điều vượt ngoài tưởng tượng của tôi”, Phó giám đốc CDC, Anne Schuchat, nói. "Về cơ bản, những con vi khuẩn gây ác mộng nằm ngay sau vườn nhà bạn".
Mỗi năm, ước tính có khoảng 2 triệu người ở Hoa Kỳ bị nhiễm vi khuẩn kháng kháng sinh, và 23.000 người trong số đó chết.
Báo cáo được công bố ngày hôm nay là báo cáo đầu tiên thuộc loại này, dựa trên thông tin thu thập được từ Mạng lưới Kháng sinh Kháng sinh Kháng sinh của CDC. Trong đó, họ đã kiểm tra các mẫu phẩm từ gần 5.800 người khả nghi, và cứ 1/10 người trong số đó lại có kết quả dương tính đối với DNA bất thường, khiến họ có thể bị kháng thuốc điều trị.
Một phần tư các mẫu vi khuẩn mang một biến thể di truyền đặc biệt, khiến chúng có thể truyền lại khả năng kháng thuốc cho các vi khuẩn khác. Theo CDC, những mảnh DNA này chính là thứ thúc đẩy vi khuẩn kháng thuốc kháng sinh 'lan rộng như cháy rừng'.
Khi các vi khuẩn kháng kháng sinh được tìm thấy ở một người, CDC sẽ thực hiện xét nghiệm xung quanh những người mà họ đã tiếp xúc. Các nhà khoa học phát hiện ra rằng vi khuẩn có mặt ở 10% những người này, họ có thể hoặc không hề có triệu chứng.
Tiến sĩ Scuchat nói rằng điều này nghĩa là sự đề kháng kháng sinh có thể đã lan rộng ngoài sức tưởng tượng, và nó còn có thể tiếp tục lây lan hơn nữa. Những vi khuẩn thông thường cũng có thể biến thành siêu vi khuẩn.
Để chống lại mối đe dọa này, CDC kêu gọi hệ thống y tế Mỹ cần 'nhận dạng nhanh chóng' các vi khuẩn này, 'đánh giá kiểm soát nhiễm khuẩn, sàng lọc người lây nhiễm' để xem dạng kháng thuốc có lan truyền sang người khác hay không, đồng thời 'phối hợp hành động giữa các cơ sở và tiếp tục đánh giá sàng lọc.'
Tiến sĩ Schuchat nói rằng khoảng một nửa trong số những người mang vi khuẩn kháng kháng sinh có thể trở thành nguồn lây lan. Vì vậy việc kiểm soát có thể gồm các biện pháp như cách ly người nhiễm bệnh hoặc đơn giản là đội ngũ y tế chăm sóc họ cần đeo găng tay và mặc áo choàng.
Theo đánh giá của CDC, chiến lược ngăn chặn đã giúp giảm bớt số ca mắc 2 bệnh nhiễm trùng kháng thuốc từ năm 2006. Cơ quan này ước tính thêm rằng, khi thực hiện nhanh và mạnh, phản ứng có thể làm giảm đến 76% số ca nhiễm trùng trong vòng ba năm tới.
"Đây không phải là một điều mới mẻ, nhưng chúng tôi đã tăng cường năng lực của mỗi tiểu bang với 500 nhân viên mới trên khắp cả nước, nhờ phân bổ ngân quỹ cho các phòng thí nghiệm kháng kháng sinh được trao cho CDC vào năm 2016", Tiến sĩ Schuchat nói.
Giáo sư William Schaffner - một nhà nghiên cứu y tế dự phòng và chính sách làm việc tại Trường Y Đại học Vanderbilt nhận xét những nỗ lực của CDC đang tỏ ra hiệu quả trong việc tìm hiểu và ngăn chặn siêu vi khuẩn lây lan trên toàn nước Mỹ.
“Họ xác định được chính xác vấn đề và bắt đầu có những phản ứng phù hợp ngay cả ở mức cơ sở y tế địa phương và nhân viên bệnh viện”, giáo sư Schaffner nói.
Một báo cáo năm 2016 được ủy quyền bởi chính phủ Anh kêu gọi đầu tư 40 tỷ USD trong thập kỷ tới để ngăn chặn vấn đề kháng kháng sinh trên toàn cầu. Khoảng 700.000 người trên thế giới chết vì kháng thuốc mỗi năm. Theo báo cáo, nếu không có hành động ngay lập tức, số ca tử vong hàng năm có thể tăng lên 10 triệu người vào năm 2050.
Vi khuẩn tiến hóa tự nhiên để chống lại các loại thuốc kháng sinh của con người từng giết chết chúng. Thuốc kháng sinh càng được sử dụng nhiều hơn, điều này càng xảy ra nhanh hơn. Trong khi phát triển các loại thuốc kháng sinh mới sẽ giải quyết được một phần vấn đề, nó giống như việc tự đào sâu xuống hố để thoát khỏi nó.
Điều quan trọng hơn nhiều là tất cả các quốc gia trên thế giới phải chung tay sử dụng kháng sinh một cách thận trọng hơn. Nhiều bác sĩ ngày nay thường kê toa kháng sinh khi không cần thiết. Trong khi đó, ở các nước đang phát triển, bệnh nhân có thể dễ dàng mua kháng sinh mà không cần đơn kê của bác sĩ. Kháng sinh cũng đang bị lạm dụng rất nhiều trong chăn nuôi.
Theo ZKnight (Trí Thức Trẻ)








- Hưng Yên triệt phá đường dây cá độ World Cup 2026 hơn 10 tỷ đồng, bắt 10 người (6 phút trước)
- Tin mới nhất về bão số 1 Maysak: Diễn biến khó lường, đêm 3/7 - 5/7 mưa rất to ở Đông Bắc Bộ, Thanh Hóa (8 phút trước)
- Sự trùng hợp đầy nghiệt ngã từ một bản hit cũ: Khi cả 3 ngôi sao của MV đều lần lượt bị bắt (10 phút trước)
- Hai tuần tới, 2 con giáp được vận may ghé thăm: Tài lộc khởi sắc, nợ nần dần tháo gỡ, chuyện tình cảm cũng nhiều tín hiệu tích cực (11 phút trước)
- Bố mẹ nói cho vay 200 triệu xây nhà, con gái đếm lại phát hiện 300 triệu, quyết định sau đó khiến chồng đòi ly hôn (26 phút trước)
- PNJ chịu áp lực bán mạnh, cổ phiếu giảm sàn sau thông tin điều tra liên quan công ty thành viên (35 phút trước)
- Cháy căn nhà 4 tầng ở Hà Nội lúc 13h khiến hàng xóm hoảng loạn: Nghi có người còn mắc kẹt bên trong (38 phút trước)
- Khi Trúc Nhân làm nhiếp ảnh gia cho ba mẹ, bộ ảnh du lịch bỗng hóa "series hài" (49 phút trước)
- Nga tăng tốc nâng cấp UAV cảm tử, Ukraine đối mặt sức ép lớn khi vũ khí đánh chặn dần thất thế (50 phút trước)
- Đau bụng kéo dài, người đàn ông 67 tuổi phát hiện phình động mạch chủ bụng dọa vỡ (53 phút trước)
Bài đọc nhiều










